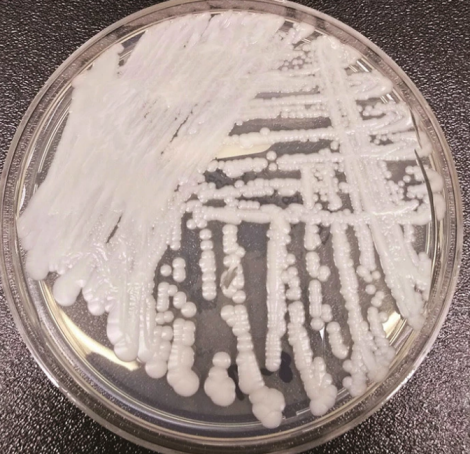
超級真菌容易感染嗎 超級真菌怎么預防

時間:2019-04-11 11:05:52來源:本站整理作者:fy點擊:
超級真菌在全美的感染病例在不斷上升,高達60%的致死率也讓很多人開始擔心,針對超級真菌的易感染人群,需要提前做好預防工作,那么超級真菌容易感染嗎?怎么預防?下面八寶網帶來介紹。

健康人群不需要預防“超級真菌”
專家指出,耳念珠菌之所以被稱為“超級真菌”,一是因為耳念珠菌耐藥性比較強,部分耳念珠菌菌株對臨床常用的三大類抗真菌藥都有耐受性(包括唑類、多烯類和棘白霉素類藥物)。二是血液感染致死率高。
另外,它在環境中生存時間比較長,能長時間存活于患者和醫護人員的皮膚及醫院設施表面,從而導致院內暴發性感染。“比如病房里有一個病人感染了,耳念珠菌通過床單、醫療器械或者其他途徑,傳給其他病人。英國有一個比較典型的例子,是耳念珠菌通過溫度計導致患者之間的交叉感染。”專家說。
患者感染后會出現什么癥狀?可以治愈嗎?專家告訴記者,實際上,感染耳念珠菌的人本身就是ICU病房的人,感染的癥狀最終都是器官衰竭。
專家指出,此前中國發現的首例耳念珠菌菌株對抗真菌藥物敏感,常用抗真菌藥物治療有效。從國外的情況看,也只有很少一部分耳念珠菌菌株對所有藥物耐藥,治療較難。
另外,從“殺傷力”來看,研究發現“超級真菌”中國分離株在毒性方面比臨床上常見的白色念珠菌還要弱。
有什么辦法避免感染嗎?專家表示,因為耳念珠菌發現時間不長,研究者較少,所以它的來源尚不明確。中國發現的患者很少,沒有流行病學調查的基礎,所以研究也很少。目前國外有研究者認為,耳念珠菌是人體自身攜帶的一種共生菌,可能存在于皮膚或腸道里。但它到底存在于什么地方,現在還不清楚。
不過,專家提醒,耳念珠菌只可能感染免疫缺陷人群,主要是ICU病房里的人,健康人群不會感染,“對健康人群沒有什么影響,也不需要預防。”
“超級真菌”出現受多重因素影響
“超級真菌”的出現,和抗生素濫用有關嗎?專家指出,目前國內外學者還未發現耳念珠菌是如何出現的,但總體上與人類生活方式、醫療方式有關系。因為20世紀50年代以前,念珠菌感染相對較少,后來變得越來越多。
他表示,耳念珠菌和其他念珠菌感染日益增多,原因大致相同。一是存在免疫缺陷的人越來越多,隨著醫療技術進步,人的壽命延長,年老后免疫功能也變得較弱,而且癌癥化療等新醫療技術的應用,讓免疫系統變得有缺陷。另外,艾滋病的流行也是導致真菌感染的原因之一;臨床上抗生素的大量應用也有影響。
超級真菌預防方法
1.單間隔離定植或感染者,要求單間有獨立的衛浴設施。
2.對于從感染的醫院或國外醫院轉來的患者,均采取隔離措施,直至獲得篩查結果。
3.嚴格遵守標準預防措施,用流動水和皂液洗手,再用速干手消毒劑消毒雙手。
4.個人防護裝備如手套和圍裙,如果有接觸患者皮膚或患者血液、體液風險,應穿隔離衣。

5.個人防護用品應在洗手后、進入房間或患者區域前穿戴好,并在患者房間內脫下并丟棄,離開前應徹底洗手并用速干手消毒劑擦拭雙手。
6.護目鏡和面罩只是在有溢出或潑濺風險時才需要佩戴。
7.患者和探視者需要掌握感染預防措施(可以使用宣傳冊),包括手衛生和如何使用圍裙。
8.應考慮使用一次性物品,如血壓計袖帶、枕頭等,特別是在暴發期間。
以上就是超級真菌容易感染嗎,超級真菌怎么預防,請大家繼續關注。
網友跟帖
Copyright 2015-2020 8bb.com 〖八寶網〗 版權所有 鄂ICP備19016373號-1
聲明: 本站文章均來自互聯網,不代表本站觀點 如有異議 請與本站聯系 本站為非贏利性網站 不接受任何贊助和廣告
網友評論僅供其表達個人看法,并不表明八寶網立場。